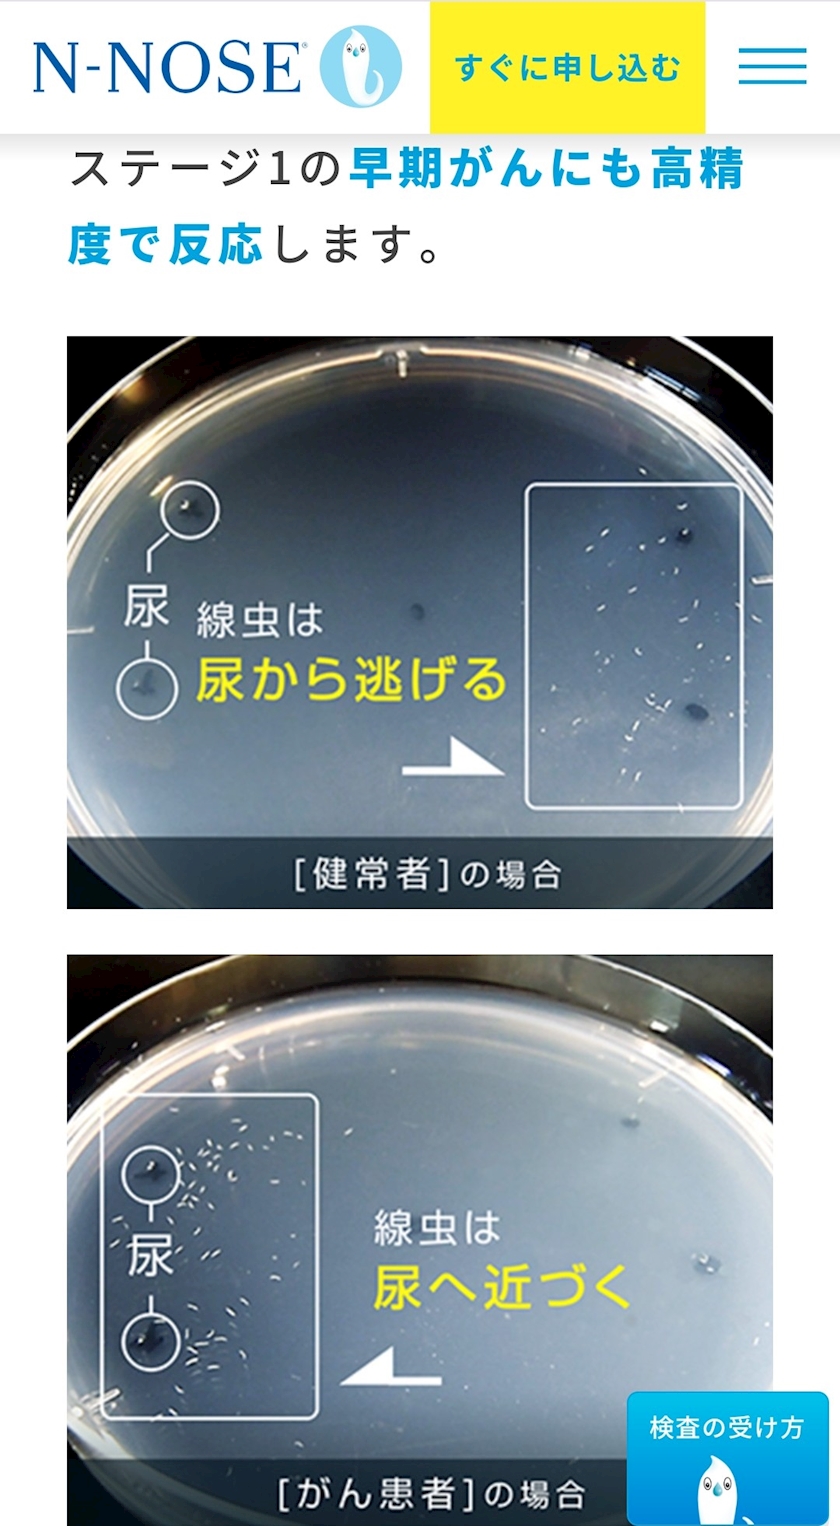

線虫がん検査 - あくび(AKB) - 大阪 熟女キャバクラ・Mrs.J ミナミ
掲載店舗:630店 女の子:10782人
Mrs.J ミナミ (ミセスジェイ)
ミナミ 熟女キャバクラ
大阪府大阪市中央区東心斎橋2丁目3番17号 パピヨンビル 3F
TEL:06-4963-3720
★ |
★ |
★ |
線虫がん検査
2023年07月25日 13時00分

先日、大阪メトロの御堂筋線で広告されてた
『線虫がん検査』
尿を採取して送るだけの手軽さや、全身15種類もの検査ができるのに、リーズナブル♪
興味が出てきたので、一度買って調べてみようかなぁ~



当店で働いて頂ける
キャスト・スタッフをご紹介頂いた場合は
下記の謝礼金を進呈いたします


プロフィール
名前:あくび(AKB)
T160
肩書き:昭和の団地妻風
血液型:不明
前職:OL・今もOLしています。
出身地:兵庫県
誕生日:9月25日
お酒・タバコ:普通・吸わない
最近のブログ
-
H2Oマッサージ/誕生日プ...
3月26日 11:00
スーパーイイネ!(18)イイネ!(25)コメント(0) -
ご来店、有難うございました...
3月26日 0:40
スーパーイイネ!(41)イイネ!(69)コメント(0) -
出勤します💨
3月25日 18:35
スーパーイイネ!(31)イイネ!(47)コメント(0) -
記者になったお客様
3月25日 13:00
スーパーイイネ!(28)イイネ!(62)コメント(0) -
ご来店、有難うございました...
3月25日 1:25
スーパーイイネ!(26)イイネ!(51)コメント(0) -
出勤します💨
3月24日 18:35
スーパーイイネ!(33)イイネ!(54)コメント(0) -
すみ吉☆おでん
3月24日 13:00
スーパーイイネ!(29)イイネ!(50)コメント(0) -
ご来店、有難うございました...
3月24日 1:51
スーパーイイネ!(27)イイネ!(55)コメント(0) -
出勤します💨
3月23日 18:35
スーパーイイネ!(19)イイネ!(43)コメント(0) -
ご来店、有難うございました...
3月23日 11:00
スーパーイイネ!(31)イイネ!(51)コメント(0)
過去のブログ
| 住所 |
|---|
|
大阪府大阪市中央区東心斎橋2丁目3番17号 パピヨンビル 3F |
| 営業時間 |
| 19:00~LAST |
| Webサイト |
| オフィシャルHP |
| 系列店情報 |
【梅田】Mrs.J 梅田
【木屋町】Mrs.J 木屋町
|
| その他情報 |
|

【梅田】Mrs.J 梅田
【木屋町】Mrs.J 木屋町
